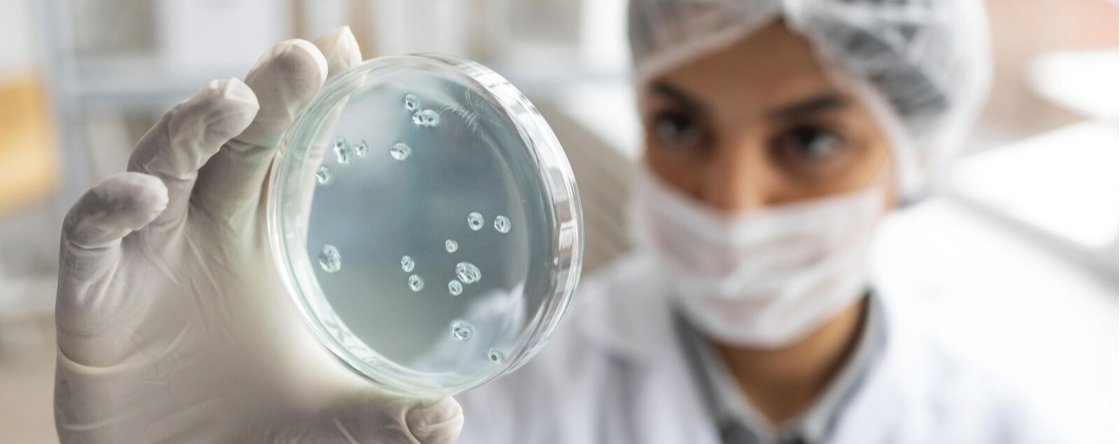
Akkermansia Muciniphila, il batterio alleato della salute

Akkermansia Muciniphila, il batterio alleato della salute
Negli ultimi anni, la ricerca scientifica ha evidenziato il ruolo centrale che il microbiota intestinale ricopre per il benessere generale. In questo ecosistema complesso, il batterio Akkermansia muciniphila ha assunto un ruolo di primo piano grazie alla sua capacità di agire direttamente sulla barriera intestinale e sui meccanismi metabolici.
Cos’è l’Akkermansia Muciniphila?
Si tratta di un microrganismo che si distingue per la sua abilità nel degradare la mucina intestinale, rafforzando così lo strato protettivo che riveste l’epitelio e, se da un lato la sua presenza sembra fondamentale per il mantenimento di un corretto equilibrio intestinale, una sua carenza è stata osservata in persone affette da patologie croniche, tra cui obesità, infiammazioni intestinali, diabete e disturbi metabolici.
In tempi recenti, la comunità scientifica ha mostrato un crescente interesse nei confronti della relazione tra microbiota e cancro, evidenziando come la composizione microbica intestinale, e in particolare la presenza di Akkermansia, possa influenzare l’efficacia di alcune terapie immunologiche.
Akkermansia Muciniphila e diabete
Tra le applicazioni più promettenti di Akkermansia muciniphila vi è il supporto nella gestione del diabete, sia di tipo 1 che di tipo 2, in quanto diversi studi preclinici e clinici hanno rilevato che questo batterio può favorire un miglior controllo glicemico attraverso vari meccanismi.
In particolare, la sua azione sulla regolazione del glucagon-like peptide-1 (GLP-1) contribuisce a modulare l’assorbimento degli zuccheri e a potenziare la sensibilità insulinica, aspetto particolarmente rilevante per chi ha necessità di misurare la glicemia frequentemente o presenta una condizione di insulino-resistenza.
La somministrazione di Akkermansia muciniphila probiotico, soprattutto nella sua forma pastorizzata, ha dimostrato una buona tollerabilità e risultati incoraggianti anche nei soggetti con sindrome metabolica: miglioramenti significativi sono stati osservati non solo nei valori glicemici, ma anche nei livelli di colesterolo e nella resistenza insulinica, suggerendo un potenziale uso preventivo e terapeutico.
Benefici gastrointestinali e gestione del peso
Come anticipato, l’Akkermansia muciniphila svolge un’azione diretta sulla mucosa intestinale, favorendo la produzione e il rinnovamento dello strato di muco che riveste il tratto gastrointestinale. Questo processo contribuisce a rendere la barriera intestinale più resistente agli agenti patogeni e alle tossine, riducendo l’infiammazione locale e migliorando la funzionalità intestinale. Non a caso, questo probiotico è stato al centro di numerose ricerche sui disturbi gastrointestinali, compresa la sindrome dell’intestino irritabile.
Dal punto di vista metabolico, il batterio interviene anche sul metabolismo dei grassi, infatti, la sua presenza è stata correlata a una minore assimilazione dei lipidi alimentari e a una maggiore attività dei mitocondri, con un impatto positivo sul dispendio energetico. Questi effetti risultano particolarmente utili per chi si trova in una condizione di sovrappeso o fatica a perdere peso, soprattutto se in presenza di squilibri ormonali o metabolici. Questo probiotico risulta utile in quanto aiuta a ridurre i livelli di insulina e a migliorare la capacità dell’organismo di utilizzare il glucosio, contrastando quei meccanismi che favoriscono l’accumulo adiposo.
Non meno importante, il rafforzamento della barriera intestinale, inoltre, ha un effetto sistemico: una mucosa più resistente contribuisce a una minore attivazione del sistema immunitario e a un’infiammazione cronica ridotta, due condizioni spesso implicate nell’insorgenza di malattie metaboliche e autoimmuni.
Prodotti correlati
Negli ultimi anni sono stati sviluppati diversi integratori alimentari formulati per garantirsi un buon apporto di Akkermansia muciniphila o per stimolarne la crescita naturale nel tratto intestinale.
Gestione Del Peso The Akkermansia Company
Integratore pensato per chi desidera un sostegno metabolico mirato alla regolazione del peso corporeo e del metabolismo glicemico, grazie a una formulazione indicata per supportare la riduzione del grasso corporeo e contribuire al mantenimento di una glicemia stabile. Agisce in sinergia con l’attività fisica e una dieta equilibrata, migliorando la sensibilità insulinica e promuovendo il benessere metabolico complessivo.
Una formulazione base pensata per il sostegno quotidiano dell’ecosistema intestinale, in formato capsule contenenti un estratto selezionato di Akkermansia, trattato per garantire la massima efficacia e sicurezza. Questo prodotto è indicato in tutte le situazioni in cui si vuole favorire l’equilibrio del microbiota intestinale, migliorare la resistenza della barriera mucosa e sostenere la risposta immunitaria.
Comfort Intestinale The Akkermansia Company
Formulato per il benessere intestinale, questo integratore è rivolto a chi presenta disturbi del transito o sintomi legati a disbiosi, in quanto aiuta a ridurre gonfiore, tensione addominale e irregolarità, grazie alla sua azione mirata sulla mucosa e sull’ambiente microbico intestinale. La sua assunzione contribuisce a riequilibrare la flora intestinale e a migliorare la funzionalità digestiva, anche nei soggetti con intestino sensibile o predisposizione a infiammazioni croniche.
Se hai bisogno di altri consigli, contattaci! Il nostro team di professionisti sarà felice di risponderti.

.png)










